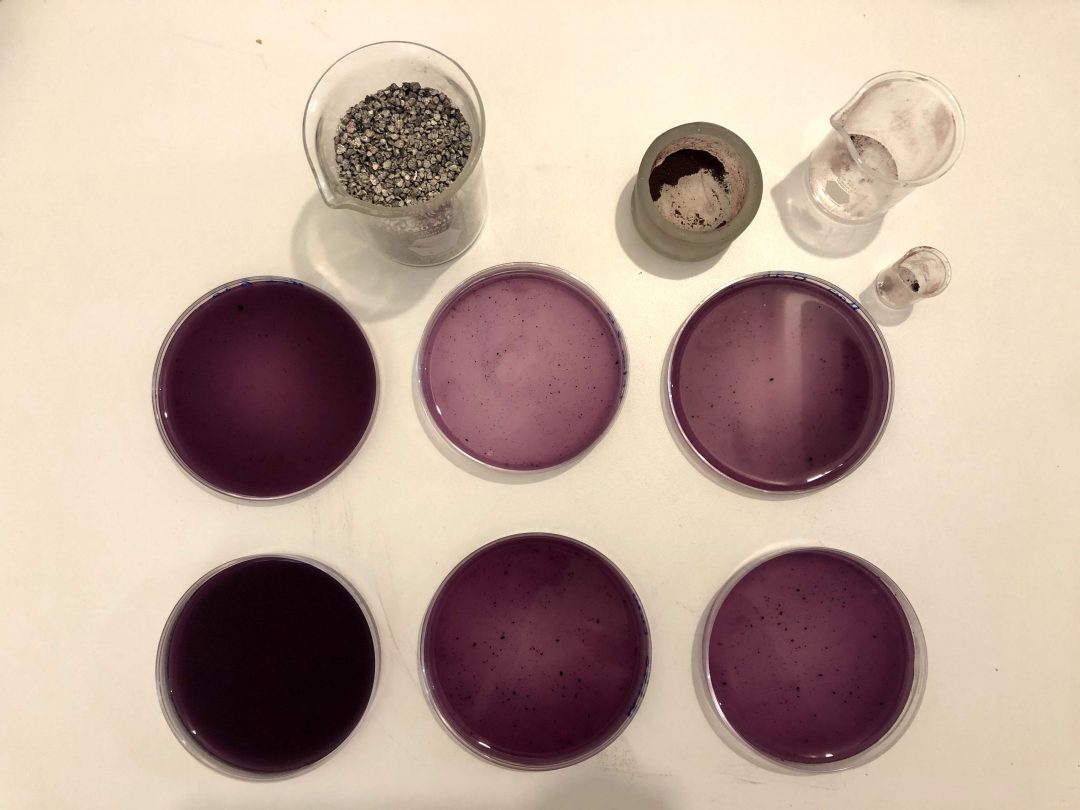
Speculative Materials

CV Maro
Maro Pebo. Born in Mexico City. PhD in Creative Media at City University of Hong Kong, MA in Gender Studies at Bologna University and BA in Art History at Iberoamerican University in Mexico City. Specializes in the intersections of art, science, and biotechnology. Her...
Teaching and Public Speaking.
1) Visual Ethnography. City University of Hong Kong 2) Moist Media / Bioart. Roy Ascott's DeTao Masters Academy. Shanghai Institute of Visual Arts 3) Comparative paradigms / Art Theory. 4) Cyberception. 5) Professional development for artists. Selected Public Speaking...
“Imagination and Accountability: Grounding Possible Futures in Art and Biology Artefacts”
Paper presented at the 16th Biennial Symposium for Arts and Technology at The Ammerman Center for Arts and Technology at Connecticut College on February 15, 16 and 17, 2018. Abstract We are eager to move on from what feels like an obsolete theoretical frame. It is...
Indomitable mechanisms: Bacteria as wet machine @Politics of the Machine, art and after.
Mariana Pérez Bobadilla. Indomitable mechanisms: Bacteria as wet machines. Abstract: In their relative simplicity, bacteria enact wet machines with more clarity than other organisms. Gene editing has turned them into a preexisting mechanism that can be...
Toyama Marathon
I wished a typhoon would come and the race would be canceled. I was terrified, I had never run more than 30 km and know I was for the first time in Japan trying to face the constraints we set to ourselves. My resistance was so great that I made a hotel reservation for...
Axolotl Albino
The Mexican salamander (Ambystoma mexicanum) native and endemic to present-day Mexico City, usually dark green and exceptionally mutating to albino. One of my favourite animals, fascinating in terms of the impossibility of overcoming unintelligibility as in "Axolot"...
10 Km
Corrí 10 Km por primera vez con mi hermana, Ciudad Universitaria a 2400 metros sobre el nivel del mar, sólo 100 metros de desnivel. Pero fue suficiente para hacerme sentir que se me escapaba el alma. Terminamos en una hora, pero por primera vez sentí la altura de...
¿Con qué tenis correr?
Entre los deportes correr me parecía el menos consumista, sin necesitar inscripciones, campos, instrumentos es una forma de ejercitarse rebelde que puede ejecutarse en cualquier momento. El capitalismo toca todas nuestras actividades y deseos, existen muchisimos...
Empezar a correr
Siempre había corrido con mi mamá, pero fue la última carrera de 5k que me hizo darme cuenta que era algo que disfrutaba y necesitaba comenzar a hacer mejor. Pensé para mi lista antes de los 30 incluir un medio maratón. Una querida amiga me sugirió tirarle...
La escritura como pensamiento
Aunque genera una gran sensación de vulnerabilidad, publicar la escritura y el pensamiento les otorga todo un sentido al que no pueden acceder como textos secretos en papeles que se erosionarán y borrarán, sin la oportunidad de ser debatidos, de fertilizar o catalizar...